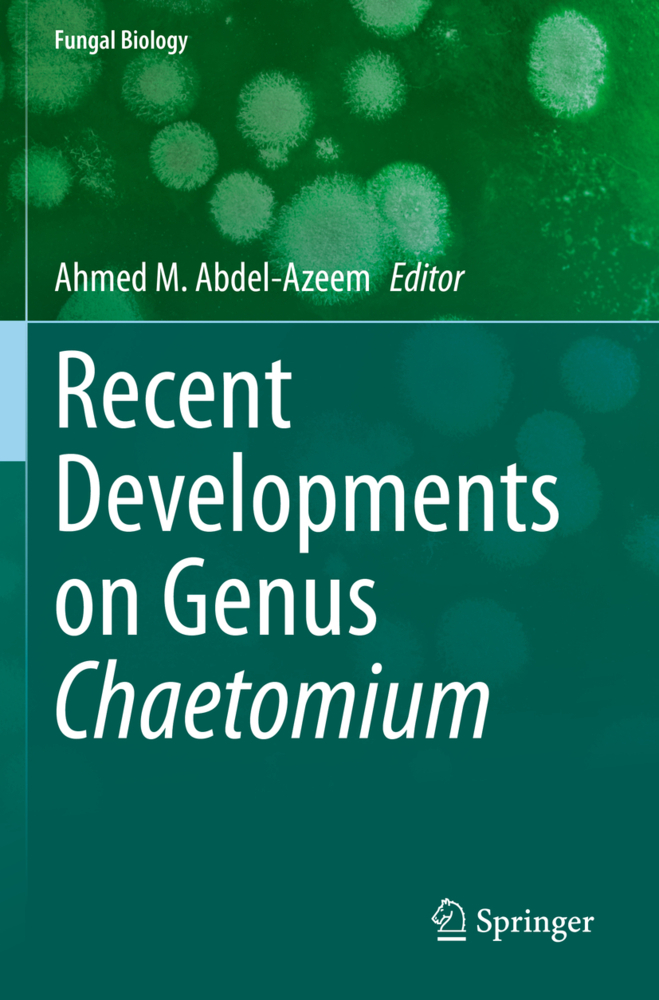

Exploring the Realms of Nature for Nanosynthesis
Exploring the Realms of Nature for Nanosynthesis
Nature, by dint of its constitution, harbors many unassuming mysteries broadly manifested by its constituent cohorts. If physics is the pivot that holds nature and chemistry provides reasons for its existence, then the rest is just manifestation. Nanoscience and technology harbor the congruence of these two core subjects, whereby many phenomenon may be studied in the same perspective. That nature operates at nanoscale-obeying the principles of thermodynamics and supramolecular chemistry-is a well understood fact manifested in a variety of life processes: bones are restored after a fracture; clots potentially leading to cerebral strokes can be dissolved. The regeneration of new structures in our system follows a bottom-up approach. Be it a microbe (benign or pathogenic), plant (lower or higher), plant parts/organs, food beneficiaries, animal (lower), higher animal processing wastes, these all are found to deliver nanomaterials under amenable processing conditions. Identically, the molecules also seem to obey the thermodynamic principles once they get dissociated/ionized and the energy captured in the form of bonding helps in the synthesis of a myriad of nanomaterials. This edited volume explores the various green sources of nanomaterial synthesis and evaluates their industrial and biomedical applications with a scope of scaling up. It provides useful information to researchers involved in the green synthesis of nanomaterials in fields ranging from medicine to integrated agricultural management.
2.Microbes: Nature's Cell Factories of Nanoparticles Synthesis: Tabeer Khan, Sidra Abbas, Anila Fariq and Azra Yasmin
3. Myco-Nanoparticles: A Novel Approach for Inhibiting Amyloid-beta Fibrillation: Aditya Saran, Rajender Boddula, Priyanka Dubey, Ramyakrishna Pothu and Saurabh Gautam
4. Synthesis and Characterization of Selenium Nanoparticles Using Natural Resources and Its Applications: S. Rajeshkumar, P. Veena and R.V. Santhiyaa
5. Nanofabrication by Cryptogams: Exploring the Unexplored: Sabiha Zamani, Babita Jha, Anal K. Jha and K. Prasad
6. Plant and Its Biomolecules on Synthesis of Silver Nanoparticles for the Antibacterial and Antifungal Activity: S. Rajeshkumar, R.V. Santhiyaa and P. Veena
7. Plants as Fabricators of Biogenic Platinum Nanoparticles: A Gambit Endeavour: Babita Jha, Anal K. Jha and K. Prasad
8. Hidden Treasures for Nanomaterials Synthesis: Niraj Kumari, Priti Kumari, Anal K. Jha and K. Prasad
9. Synthesis of Functionalized Nanoparticles for Biomedical Applications: Priti Kumari, Niraj Kumari, Anal K. Jha, K.P. Singh and K. Prasad
10. Degradation Dye Using Gold and Silver Nanoparticles Synthesized by Using Green Route and Its Characteristics: Rajeshkumar and R. V. Santhiyaa
11.Nanomaterials: An Upcoming Fortune to Waste Recycling: Mugdha Rao, Anal K. Jha and K. Prasad
12. Synthesis of Nanomaterials Involving Microemulsion and Miceller Medium: Santosh Kumar, Mohammad Y. Wani and Joonseok Koh
13. Hydrothermal Nanotechnology: Putting the Last First: Sumit K. Roy and K. Prasad
14. Hydrothermal Synthesis of Hybrid Nanoparticles for Future Directions of Renewal Energy Applications: G. P. Singh, Neha Singh, Ratan Kumar Dey and K. Prasad
15.Biomedical Applications and Characteristics of Graphene Nanoparticles and Graphene-Based Nanocomposites: S. Rajeshkumar and P. Veena
16. Nanodiagnostics Tools for Microbial Pathogenic Detection in Crop Plants: Sandra Pérez Álvarez, Marco Antonio Magallanes Tapia, Jesús Alicia Chávez Medina, Eduardo Fidel Héctor Ardisana and María Esther González Vega
17. Nanocrystalline Cellulose - Production and Applications: Sai Swaroop Dalli, Bijaya Kumar Uprety, Mahdieh Samavi, Radhika Singh and Sudip Kumar Rakshit
Index.
Preface
1. Mechanistic Plethora of Biogenetic Nanosynthesis: An Evaluation: Anal K. Jha and K. Prasad2.Microbes: Nature's Cell Factories of Nanoparticles Synthesis: Tabeer Khan, Sidra Abbas, Anila Fariq and Azra Yasmin
3. Myco-Nanoparticles: A Novel Approach for Inhibiting Amyloid-beta Fibrillation: Aditya Saran, Rajender Boddula, Priyanka Dubey, Ramyakrishna Pothu and Saurabh Gautam
4. Synthesis and Characterization of Selenium Nanoparticles Using Natural Resources and Its Applications: S. Rajeshkumar, P. Veena and R.V. Santhiyaa
5. Nanofabrication by Cryptogams: Exploring the Unexplored: Sabiha Zamani, Babita Jha, Anal K. Jha and K. Prasad
6. Plant and Its Biomolecules on Synthesis of Silver Nanoparticles for the Antibacterial and Antifungal Activity: S. Rajeshkumar, R.V. Santhiyaa and P. Veena
7. Plants as Fabricators of Biogenic Platinum Nanoparticles: A Gambit Endeavour: Babita Jha, Anal K. Jha and K. Prasad
8. Hidden Treasures for Nanomaterials Synthesis: Niraj Kumari, Priti Kumari, Anal K. Jha and K. Prasad
9. Synthesis of Functionalized Nanoparticles for Biomedical Applications: Priti Kumari, Niraj Kumari, Anal K. Jha, K.P. Singh and K. Prasad
10. Degradation Dye Using Gold and Silver Nanoparticles Synthesized by Using Green Route and Its Characteristics: Rajeshkumar and R. V. Santhiyaa
11.Nanomaterials: An Upcoming Fortune to Waste Recycling: Mugdha Rao, Anal K. Jha and K. Prasad
12. Synthesis of Nanomaterials Involving Microemulsion and Miceller Medium: Santosh Kumar, Mohammad Y. Wani and Joonseok Koh
13. Hydrothermal Nanotechnology: Putting the Last First: Sumit K. Roy and K. Prasad
14. Hydrothermal Synthesis of Hybrid Nanoparticles for Future Directions of Renewal Energy Applications: G. P. Singh, Neha Singh, Ratan Kumar Dey and K. Prasad
15.Biomedical Applications and Characteristics of Graphene Nanoparticles and Graphene-Based Nanocomposites: S. Rajeshkumar and P. Veena
16. Nanodiagnostics Tools for Microbial Pathogenic Detection in Crop Plants: Sandra Pérez Álvarez, Marco Antonio Magallanes Tapia, Jesús Alicia Chávez Medina, Eduardo Fidel Héctor Ardisana and María Esther González Vega
17. Nanocrystalline Cellulose - Production and Applications: Sai Swaroop Dalli, Bijaya Kumar Uprety, Mahdieh Samavi, Radhika Singh and Sudip Kumar Rakshit
Index.
Prasad, Ram
Jha, Anal K.
Prasad, Kamal
| ISBN | 978-3-030-07612-2 |
|---|---|
| Medientyp | Buch |
| Copyrightjahr | 2018 |
| Verlag | Springer, Berlin |
| Umfang | XIV, 414 Seiten |
| Abbildungen | XIV, 414 p. 120 illus., 113 illus. in color. |
| Sprache | Englisch |